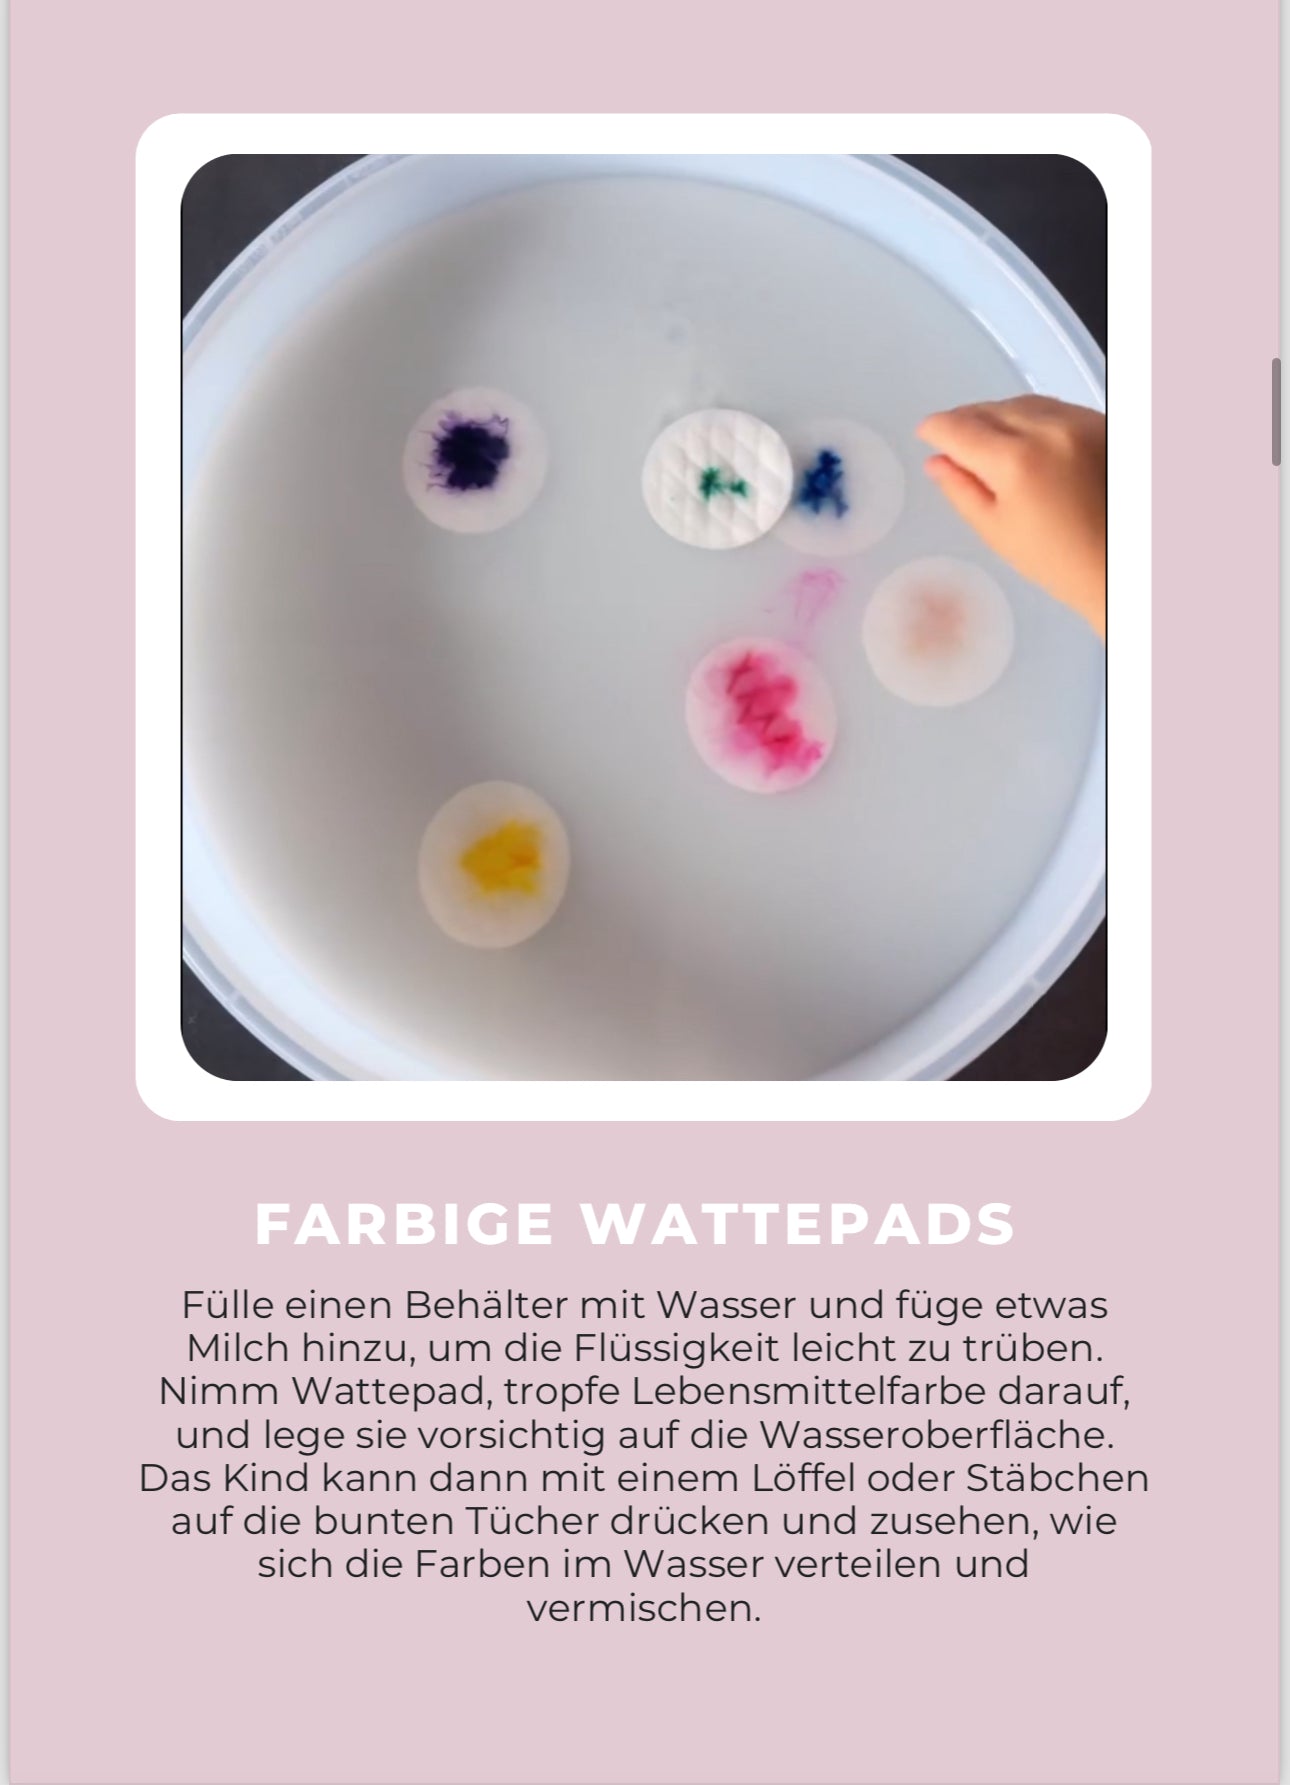

1
/
von
6
A-Kids
50 Spielideen für zuhause - Kinder fördern leicht gemacht (Digital)
50 Spielideen für zuhause - Kinder fördern leicht gemacht (Digital)
3-4 Werktage Lieferzeit
Kostenloser Versand für Bestellungen aus dem Inland ab 50 €
Normaler Preis
€14,99 EUR
Normaler Preis
Verkaufspreis
€14,99 EUR
Grundpreis
/
pro
Inkl. Steuern.
Versand wird beim Checkout berechnet
Verfügbarkeit für Abholungen konnte nicht geladen werden
Sofort Download Link - Als Eltern von drei Kindern haben wir eine Sammlung von 50 kreativen und abwechslungsreichen Spielen zusammengestellt, die uns durch viele wertvolle Momente begleitet haben.
Jedes Spiel ist darauf ausgelegt, die ganzheitliche Entwicklung Ihres Kindes zu fördern – von motorischen Fähigkeiten bis hin zur Stärkung der Kreativität.
Perfekt geeignet für Kinder bis 2,5 Jahre
Share